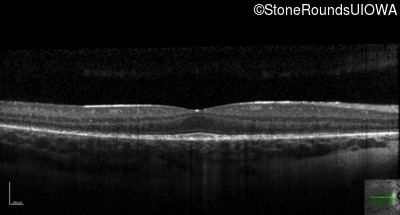
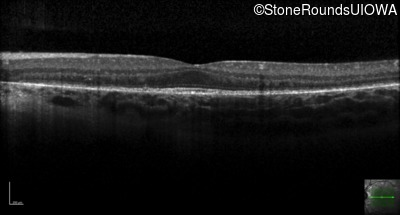

Case
SR1079
Student Mode
XL Choroideremia (IIIA1a)
Male
Male
Hidden
SR1079
Student Mode
XL Choroideremia (IIIA1a)
Male
Male
History
This 11 year old boy first had some fundus abnormalities noted during a routine eye exam at age 8. He remains asymptomatic. He has no difficulties seeing in dim light.
Diagnosis & molecular findings
| Disease | Gene | Allele 1 variant(s) | Allele 2 variant(s) | Inheritance mode |
|---|---|---|---|---|
| XL Choroideremia | CHM | Thr300ins1cttA | XL |